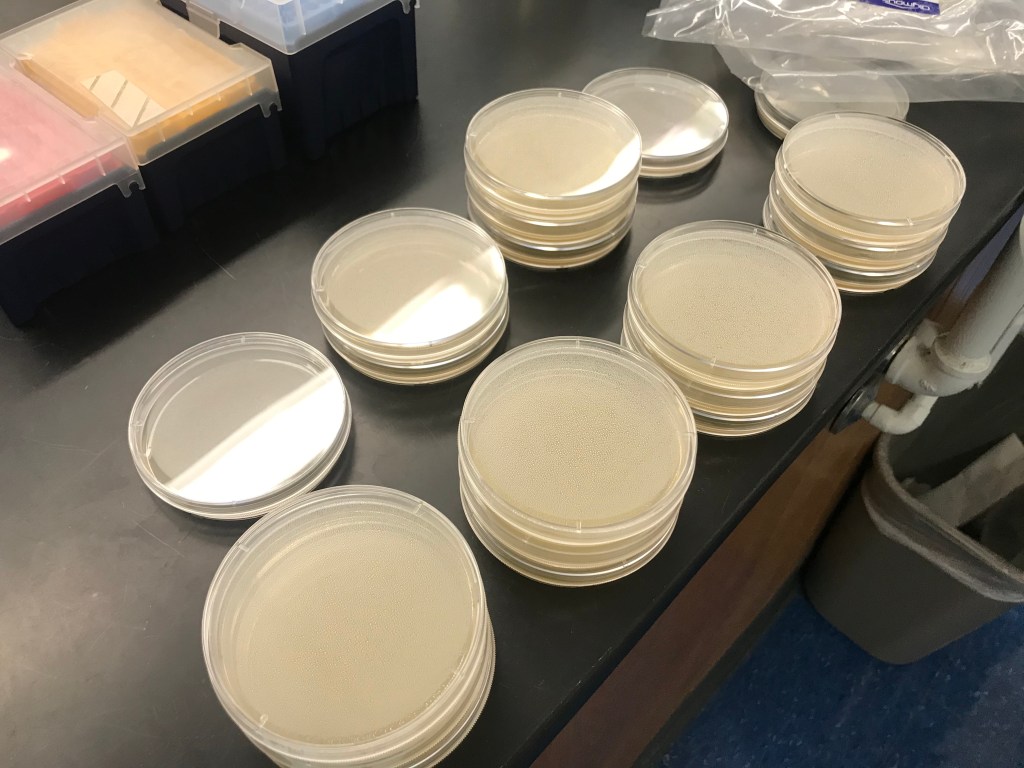

By Crystal Yang
If you’ve ever gotten lost in the Libra Complex, you’ve probably wondered, “Will I ever find my way out?” You might have asked, “How will I survive? How long will I last? What will I eat?” Well, have no fear, for here is your guide to where you can acquire snacks to satiate your hunger and survive to see another day in the vast labyrinth that is the Libra Complex.





Vending Machines: The vending machines in Beckman Basement can come in handy in a pinch, but for a price. That said, these machines are cheaper than your typical ones and are well stocked with a good variety of snacks.
Stauffer Lounge: The Physics Department is fully stocked. They also have free coffee!

Digital & Analog Labs: Resistors make a good light snack. They’re delightfully crunchy and come in different colors and flavors, but their legs can tickle when going down, so we recommend that you trim them first with wire strippers (or your teeth).
Big Beckman: Sometimes, CS kids will wander into Big Beckman late at night. Since they’re always hunched over computers, they’re nice and tender, and also have excellent marbling. They make great ribs!

Pretty Much Any Lab With Computers: If you’re particularly desperate, busting open computers will get you crispy chips.
E79 Tank Room: Feeling thirsty? Quench your thirst with the bright blue water of the tank room! PVC straws provided. Hydrate or Diedrate!

Prof. Ilton’s Office: Prof. Ilton has coffee and tea in his office and occasionally stocks up on snacks that he doesn’t find tempting so that he doesn’t snack too much himself. He also provides great conversation and kindness.
Biology Labs: The agar jelly in the bio labs is tasty and bountiful. Light and springy, these pack-and-go snacks are full of protein and also very low in calories.

Chemistry Labs: Rehydrate with ethanol and DI water, staples in the chemistry labs. 
The Engineering Computational Facility (ECF): The pen where they keep the engineering livestock. They really seem to go through them quickly because there’s a new crop every night.

Koi Pond: Forbidden snacks. The koi are rumored to taste good when cooked at dorm BBQ. 
Engineering Lounge: The engineering lounge always has free coffee and occasionally has leftovers from events. Keep your eyes out for Prof. Harris’s Engineering email alerts about food.

Engineering Stockroom: Washers and nuts make great cereal, with or without milk. If you’re feeling particularly daring, you can try nails (without the milk). 
“Fountain” Near Beckman: If you do end up finding your way out, the orange trees near the “fountain” at Beckman carry very juicy oranges when they’re ripe.
Clinic Spaces

3/10 — barely any sustenance.
7/10 — well-stocked from Target.

9/10 — can tell they went to Ranch 99.
8/10 — crunchy.

5/10 — standard snacking foods.
2/10 — only Yerba Mate.
We hope this guide will help you be more confident in braving the Libra Complex. With this guide, you won’t have to worry about starving to death (but you might have to worry about working to death).